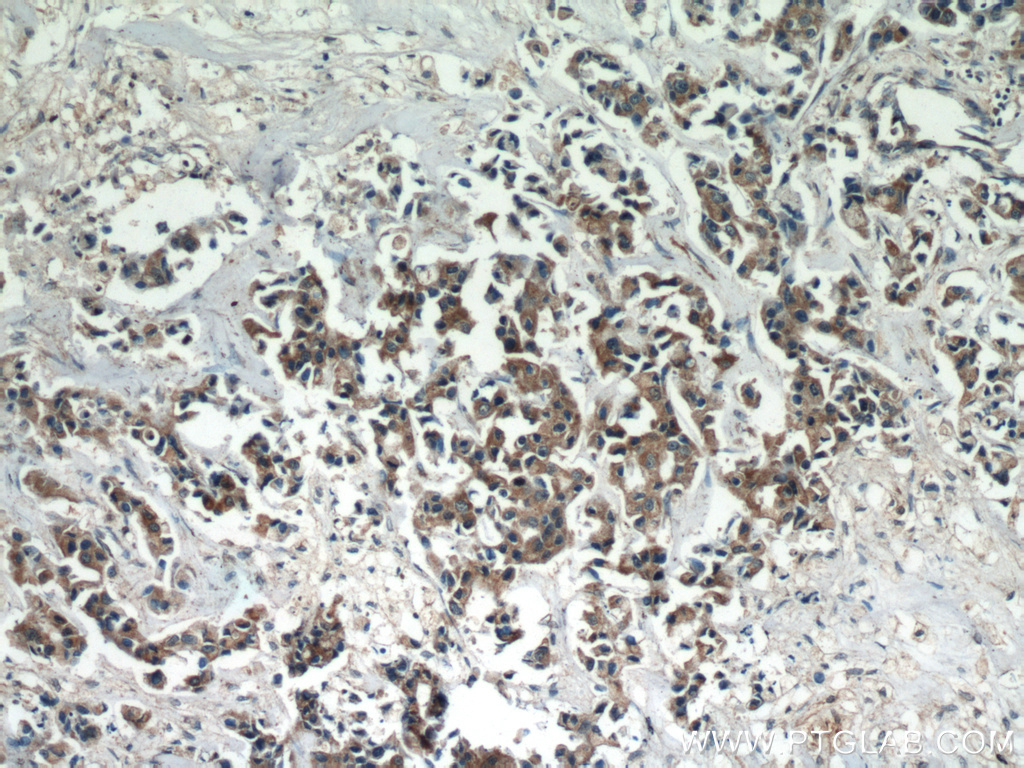

验证数据展示
产品信息
60035-1-PBS targets ATF4 in WB, IHC, IF/ICC, FC (Intra), Indirect ELISA applications and shows reactivity with human, mouse, rat samples.
| 经测试应用 | WB, IHC, IF/ICC, FC (Intra), Indirect ELISA Application Description |
| 经测试反应性 | human, mouse, rat |
| 免疫原 |
CatNo: Ag1279 Product name: Recombinant human ATF4 protein Source: e coli.-derived, PGEX-4T Tag: GST Domain: 1-351 aa of BC022088 Sequence: MTEMSFLSSEVLVGDLMSPFDQSGLGAEESLGLLDDYLEVAKHFKPHGFSSDKAKAGSSEWLAVDGLVSPSNNSKEDAFSGTDWMLEKMDLKEFDLDALLGIDDLETMPDDLLTTLDDTCDLFAPLVQETNKQPPQTVNPIGHLPESLTKPDQVAPFTFLQPLPLSPGVLSSTPDHSFSLELGSEVDITEGDRKPDYTAYVAMIPQCIKEEDTPSDNDSGICMSPESYLGSPQHSPSTRGSPNRSLPSPGVLCGSARPKPYDPPGEKMVAAKVKGEKLDKKLKKMEQNKTAATRYRQKKRAEQEALTGECKELEKKNEALKERADSLAKEIQYLKDLIEEVRKARGKKRVP 种属同源性预测 |
| 宿主/亚型 | Mouse / IgG1 |
| 抗体类别 | Monoclonal |
| 产品类型 | Antibody |
| 全称 | activating transcription factor 4 (tax-responsive enhancer element B67) |
| 别名 | 3E4C5, cAMP-dependent transcription factor ATF-4, CREB2, Cyclic AMP-responsive element-binding protein 2, Tax-responsive enhancer element-binding protein 67 |
| 计算分子量 | 39 kDa |
| 观测分子量 | 45-50 kDa |
| GenBank蛋白编号 | BC022088 |
| 基因名称 | ATF4 |
| Gene ID (NCBI) | 468 |
| RRID | AB_2058598 |
| 偶联类型 | Unconjugated |
| 形式 | Liquid |
| 纯化方式 | Protein G purification |
| UNIPROT ID | P18848 |
| 储存缓冲液 | PBS only, pH 7.3. |
| 储存条件 | Store at -80°C. The product is shipped with ice packs. Upon receipt, store it immediately at -80°C |
背景介绍
What is the molecular weight of ATF4?
The molecular weight of ATF is 38.6 kD.
What is ATF4?
Activating transcription factor 4 (ATF4), also known as cAMP-response element-binding protein 2 (CREB2), is a substrate of RSK2 and a basic leucine-zipper transcription factor (PMIDs: 16000305, 17485283).
What the function of ATF4?
ATF4 its a transcription factor that controls the transcriptional activity of mature osteoblasts. ATF4 is particularly critical for their timely onset and terminal differentiation, as well as expression of Bsp and osteocalcin. Knockout animals displayed reduction or delay in bone mineralization and have severely reduced bone volume. ATF4 is also part of the PERK-eIF2α-ATF4-CHOP apoptosis pathway, which is activated by ER stress, and it likely plays a role related to tumor cell survival (PMIDs: 18083928, 16000305, 30134550).
What is the effect of ATF4 interaction with RSK2?
ATF4 and RSK2 posttranscriptionally regulate type I collagen synthesis. Lack of RSK2 phosphorylation of AFT4 may contribute to skeletal phenotypes associated with Coffin-Lowry Syndrome (PMID: 17485283).
Where is ATF4 expressed?
ATF4 protein is predominantly expressed in osteoblasts, although its corresponding Atf4 mRNA is ubiquitously expressed (PMID: 16000305).
What regulates ATF4 expression?
ATF4 is regulated by a ubiquitin/proteasomal pathway, which is less active in osteoblasts by inhibition with MG115 (PMID: 16000305).
How does ATF4 expression affect Ocn mRNA?
Inhibition of the degradation pathway leads to ATF4 accumulation and induces Ocn mRNA expression in non-osteoblastic cells (PMID: 16000305).
Does ATF4 have the ability to induce osteoblast-specific gene expression even in non-osteoblastic cells?
Yes, ATF4, as well as other osteoblast differentiation factors, has this ability. AFT4 interactions with Runx2 can stimulate osteoblast-specific osteocalcin gene expression. (PMIDs: 16000305, 17485283)